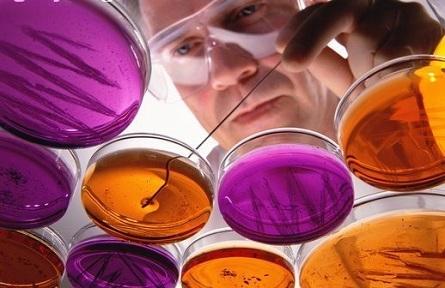

魔力果公司篩選的功能微生物菌有哪些?
近幾年,魔力果公司篩選了從國內外引進、研發(fā)的眾多功能微生物菌,一系列高效多效的有益微生物。我們選擇的幾種菌群構成為:
光合菌群:光合菌群屬于獨立營養(yǎng)微生物,菌體本身含有多種蛋白質、維生素、 葉酸、輔酶、抗病毒物質和促生長因子。它以土壤接受的光和熱為能源,將土壤中的硫氫和碳氫化合物中的氫分離出來,變有害物質為無害物質,并與植物根部的分泌物、有機質為基質合成糖類、氨基酸類、維生素類、氮素化合物、抗病毒物質和生理活性物質等,是肥沃土壤和促進動植物生長的主力軍,分泌的有機酸等活性物質可以緩慢釋放土壤中被固定的磷鉀營養(yǎng),還可與固氮菌共生,固氮能力成倍提高。
乳酸菌群:它靠攝取光合細菌、酵母菌產生的糖類形成乳酸。 乳酸具有很強的殺菌與分解復雜有機物能力,可以分解蛋白、多糖等有機物,能有效抑制有害微生物的活動和有機物的急劇腐敗分解。
酵母菌群:它利用作物根部產生的分泌物、光合菌合成的氨基酸、糖類及其它有機物產生的發(fā)酵力,合成促進根系生長及細胞分裂的活性化物質。為乳酸菌、放線菌增殖提供食物,酵母菌產生的單細胞蛋白是土壤生物不可缺少的有效養(yǎng)分。
發(fā)酵系的絲狀菌群:它對土壤中酯和抗生素的生成有良好效果,能防止蛆蟲和其它病蟲害發(fā)生,并有分離惡臭的效果。
芽孢桿菌群:主要由解淀粉芽孢桿菌、枯草芽孢桿菌、貝萊斯芽孢桿菌和巨大芽孢桿菌等組成。這些芽孢桿菌是一類廣泛分布于各種生活環(huán)境中的革蘭氏陽性桿狀細菌能夠產生內生芽孢,具有耐熱性,抗逆性強,會分泌大量的抗生素、聚谷氨酸、胞外多糖等生理活性物質,可以殺滅一些動植物中常見的病源菌,還能分泌出大量的酶、生長激素(如生長素、細胞分裂素、赤霉素等)及誘導植物產生拮抗物質,使植物產生抗病抗逆能力。
大量試驗資料證實,本公司的上述微生物種群具有繁殖速度快,耐熱抗熱性好、與化學肥料(尿素、氯化鉀、一銨等)相容性較好和生存穩(wěn)定性長等特性。在客土中具有更好的競爭位點與競爭力,繼而有更好的存活能力。更重要的是,這類菌群及其分泌物促生性好,能強烈促進農作物的初中期根系和莖葉生長及后期花、果、種子發(fā)育,增產提質效果顯著;抗病性強,能抗水稻的稻瘟病、紋枯病、玉米的大斑病,草莓和蔬菜的霜霉病、灰霉病、煙草及辣椒、香蕉的青枯病、棉花的黃萎病等。